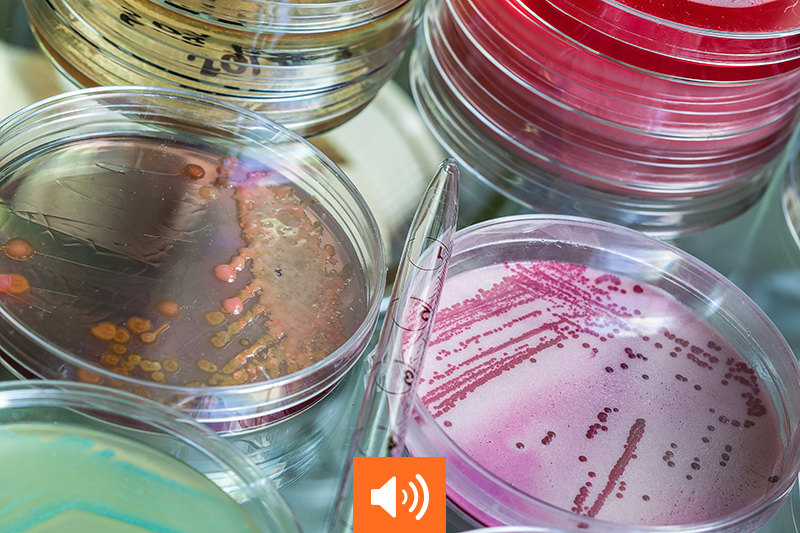

Fiches pratiques Santé et sécurité au travail
Administrations et collectivités territoriales / Assurance / BTP / BUP / ERP/IGH / Incendie/explosion / Industrie/ICPE / Santé et sécurité au travail / Sécurité civile et forces de l'ordre / Sécurité privée
Avant toute intervention en zone Atex, il est essentiel d’évaluer précisément le risque d’explosion. Une atmosphère explosive se forme lorsque des gaz, vapeurs, brouillards ou poussières combustibles se mélangent à…
Administrations et collectivités territoriales / Assurance / BTP / BUP / ERP/IGH / Incendie/explosion / Industrie/ICPE / Santé et sécurité au travail / Sécurité civile et forces de l'ordre / Sécurité privée
Face au risque d’incendie, les entreprises ont l’obligation d’assurer la protection de leurs salariés. Dans cette perspective, le référentiel Apsad R6 définit le rôle des équipiers de première intervention…
Administrations et collectivités territoriales / Assurance / BTP / BUP / ERP/IGH / Industrie/ICPE / Santé et sécurité au travail / Sécurité civile et forces de l'ordre / Sécurité privée
Comment protéger sa santé mentale et celle des autres ? Éléments de réponse avec Jean-Christophe Villette, psychologue du travail et vice-président de la Fédération des intervenants des risques psychosociaux…
Administrations et collectivités territoriales / Assurance / BUP / ERP/IGH / Industrie/ICPE / Santé et sécurité au travail / Sécurité civile et forces de l'ordre / Sécurité privée
Vacances terminées, boîte mail saturée, réunions qui s’enchaînent… La reprise du travail peut générer une forme de tension silencieuse. Pour beaucoup, le retour de congés rime avec charge mentale, fatigue,…
Administrations et collectivités territoriales / Assurance / BTP / BUP / ERP/IGH / Industrie/ICPE / Santé et sécurité au travail / Sécurité civile et forces de l'ordre / Sécurité privée
Alors qu'une personne victime de violences internes sur cinq estime avoir subi un harcèlement sexuel[1], prendre conscience de ce qui relève de ce délit ou non est capital pour…
Administrations et collectivités territoriales / BTP / BUP / ERP/IGH / Industrie/ICPE / Santé et sécurité au travail / Sécurité civile et forces de l'ordre / Sécurité privée
Les nouvelles obligations introduites par un décret et un arrêté du 27 mai 2025 pour protéger les travailleurs contre les risques liés aux épisodes de chaleur intense entrent en…
Assurer la sécurité des travaux confiés aux entreprises extérieures participe aussi de la réduction des accidents du travail. Le Code du travail pose d’ailleurs les principes devant guider ces interventions…
Les risques biologiques sont provoqués par l’action néfaste sur la santé des salariés de certains agents biologiques tels que les virus, les bactéries, les prions, les champignons microscopiques et…
Travailler en zone Atex (atmosphère explosive) présente des risques pour la santé et la sécurité des travailleurs et requiert des moyens appropriés, une formation particulière et des vêtements de…
Administrations et collectivités territoriales / Assurance / BTP / BUP / ERP/IGH / Industrie/ICPE / Santé et sécurité au travail / Sécurité privée / Sûreté / Technologies
Dispositif de contrôle d'accès souvent utilisé dans les milieux de haute sécurité, le sas de sécurité établit une zone de sécurité entre l'extérieur et le bâtiment à protéger, ou…
Assurance / BTP / BUP / ERP/IGH / Gestion des risques / Industrie/ICPE / Santé et sécurité au travail
La pyramide de Bird, élaborée par Franck Bird, permet de mener une politique de réduction des risques en estimant la probabilité de réalisation d'accidents graves par le nombre d'incidents…
Administrations et collectivités territoriales / BTP / ERP/IGH / Industrie/ICPE / Santé et sécurité au travail / Sécurité civile et forces de l'ordre
Agents chimiques CMR : établir la liste obligatoire des travailleurs exposés avant le 5 juillet 2024
Outre la fixation de nouvelles Vlep, le décret n° 2024-307 du 4 avril 2024 comprend de nouvelles dispositions visant la traçabilité de l'exposition des travailleurs aux agents chimiques CMR…
Administrations et collectivités territoriales / Assurance / BTP / BUP / ERP/IGH / Industrie/ICPE / Santé et sécurité au travail / Sécurité civile et forces de l'ordre / Sécurité privée
Les conditions à remplir pour qu'il y ait reconnaissance d'un accident du travail. Pour qu’il y ait accident du travail il faut : un fait accidentel,…
Administrations et collectivités territoriales / Assurance / BTP / BUP / ERP/IGH / Industrie/ICPE / Santé et sécurité au travail
Près de 600 000 accidents du travail et 789 décès ont été déclarés en 2022 en France. Devant l’importance de cette sinistralité, le ministère du Travail, de la Santé…
Les espaces confinés sont présents dans la plupart des secteurs d’activité. Souvent méconnus ou mal identifiés, ce sont néanmoins des lieux à risques qui peuvent se transformer en piège…
Administrations et collectivités territoriales / BTP / BUP / ERP/IGH / Industrie/ICPE / Santé et sécurité au travail
Une démarche de prévention collective, centrée sur le travail et son organisation est à privilégier. « Avec la crise sanitaire et l’arrivée massive…
L’utilisation d’une nacelle, ou Pemp (plateforme élévatrice mobile de personnel), sur un chantier suppose le respect de nombreuses règles de sécurité. Pour se former…
Le travail sur écran se pratique généralement à partir d’une posture assise et statique. Ces deux caractéristiques renferment des risques de TMS pour l’appareil locomoteur. Associées aux autres facteurs…
Administrations et collectivités territoriales / BTP / BUP / ERP/IGH / Industrie/ICPE / Santé et sécurité au travail
Qu'est-ce que le document unique (DU) ? Quelle est son utilité ? Quels risques sont pris en compte ? Comment le rédiger ? Quand le mettre à jour ?…
La prévention des risques liés à la chaleur doit être prise en compte par l’employeur dans l’évaluation des risques et transcrite dans le document unique, avec les mesures de…
Vous avez analysé vos indicateurs RPS, réalisé un diagnostic approfondi sous forme de questionnaire ou d’entretiens. Vous souhaitez maintenant construire un plan d’actions pour prévenir ou réduire les risques…
Le présent article donne des clés pour mener à bien un diagnostic RPS grâce à des entretiens et intégrer les risques psychosociaux dans le document unique (DU) d’évaluation des…
Administrations et collectivités territoriales / BTP / BUP / ERP/IGH / Industrie/ICPE / Santé et sécurité au travail / Sécurité civile et forces de l'ordre / Sécurité privée
Afin d’identifier les causes de risques psychosociaux et de les repérer, un questionnaire ou des entretiens « individuels ou collectifs » sont deux moyens à mettre en place. Cet…
Une démarche de prévention des RPS (risques psychosociaux) bien menée contribue à l’amélioration du climat social dans l’entreprise. Pour cela, la constitution du groupe projet est une étape-clé car c’est lui qui…
La gestion des RPS (risques psychosociaux) en entreprise nécessite une approche globale et exhaustive qui pourrait rebuter plus d’un responsable. Cet article est le premier d’une série qui vise à fournir les…
Santé et sécurité au travail, actus et conseils
Au 2e trimestre 2025, le nombre de plans de sauvegarde de l’emploi (PSE) validés et/ou homologués a augmenté de…
SHOWA a lancé le CC700, un nouveau produit de sa gamme ChemRest qui répond à l'un des défis…
Fondé en 2014, GAE Conseil est un cabinet de conseil spécialisé dans la prévention des addictions en entreprise. Depuis le…
Acteur majeur de l’environnement, Suez a lancé une réflexion sur la santé mentale en initiant une nouvelle politique de prévention…
Le Gouvernement a déclaré la santé mentale « grande cause nationale » en 2025. L’objectif : améliorer la connaissance et…
Le baromètre des risques Allianz 2026 a été publié le 14 janvier par Allianz Commercial. Les risques liés à…
Le décret n° 2025-1347 du 26 décembre 2025 relatif à la protection des travailleurs contre les risques dus aux…
Le décret n° 2025-1349 du 26 décembre 2025 modifie les tableaux de maladies professionnelles n° 16 bis et n°…
Ce numéro 611 du magazine Face au Risque consacre un dossier spécial à un panorama des risques 2025 -…
Le décret n° 2025-1342 du 26 décembre 2025 fixant les règles relatives à l'accessibilité lors de la construction des…